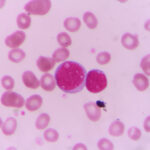

Beschreibung
Die akute Hepatitis-D-Superinfektion, auch bekannt als Delta-Hepatitis, ist eine virale Leberinfektion, die auftritt, wenn eine Person mit Hepatitis-B-Virus (HBV) mit dem Hepatitis-D-Virus (HDV) koinfiziert wird. Zu den Symptomen einer akuten HDV-Superinfektion können Gelbsucht, Müdigkeit, Bauchschmerzen, Übelkeit, Erbrechen und dunkler Urin gehören. Es gibt zwei Haupttypen von HDV-Infektionen: Koinfektion und Superinfektion. Eine Koinfektion liegt vor, wenn HDV eine Person gleichzeitig mit HBV infiziert, während eine Superinfektion vorliegt, wenn eine Person mit chronischer HBV-Infektion mit HDV infiziert wird.
Eine akute Hepatitis-D-Superinfektion ist relativ selten, kommt aber in Regionen, in denen HBV-Infektionen endemisch sind, wie in Teilen Asiens, Afrikas und des Mittelmeerraums, häufiger vor. Historisch gesehen wurde das HDV in den 1970er Jahren entdeckt und war zunächst als Delta-Erreger bekannt. Es wird angenommen, dass es von einem gemeinsamen Vorfahren des Hepatitis-B-Virus abstammt. Seit seiner Entdeckung ist die Prävalenz der HDV-Infektion in einigen Regionen aufgrund von Verbesserungen bei der HBV-Impfung und den Präventionsstrategien zurückgegangen.
Die Komplikationen einer akuten HDV-Superinfektion können schwerwiegend sein und zu fulminanter Hepatitis, Leberversagen und sogar zum Tod führen. Die Diagnose einer akuten HDV-Superinfektion umfasst in der Regel serologische Tests zum Nachweis von HDV-spezifischen Antikörpern und viraler RNA. Die Behandlungsmöglichkeiten für eine akute HDV-Superinfektion sind begrenzt und konzentrieren sich in erster Linie auf eine unterstützende Behandlung, um die Symptome zu lindern und Komplikationen zu verhindern.
Die Hauptursache für eine akute HDV-Superinfektion ist die Exposition gegenüber dem Hepatitis-D-Virus, die in der Regel durch Kontakt mit infiziertem Blut oder Körperflüssigkeiten erfolgt. Zu den Risikofaktoren für eine HDV-Infektion gehören der injizierende Drogenkonsum, ungeschützter Geschlechtsverkehr und die Geburt einer Mutter mit HBV-Infektion. Zur Vorbeugung einer akuten HDV-Superinfektion gehören Maßnahmen zur Verhinderung einer HBV-Infektion, wie z. B. Impfungen und sichere Sexual- und Injektionspraktiken.
Die Biologie dahinter
Die akute Hepatitis-D-Superinfektion betrifft in erster Linie die Leber, ein wichtiges Organ, das für zahlreiche Stoffwechsel- und Regulierungsfunktionen im Körper verantwortlich ist. Unter normalen Umständen verarbeitet die Leber Nährstoffe, entgiftet schädliche Substanzen und produziert Proteine, die für die Blutgerinnung und die Immunfunktion notwendig sind. Sie erfüllt diese Aufgaben durch das koordinierte Zusammenwirken von Hepatozyten, den wichtigsten Funktionszellen der Leber, und verschiedenen Enzymen und biochemischen Prozessen.
Bei einer Infektion mit dem Hepatitis-D-Virus (HDV) greift das Virus die Hepatozyten an, wo es sich vermehrt und eine Immunreaktion auslöst. Diese Immunreaktion, die durch die Infiltration von Entzündungszellen und die Freisetzung von Zytokinen gekennzeichnet ist, führt zu einer Entzündung und Schädigung der Leber. HDV kann die Hepatozyten direkt schädigen und ihre Funktion beeinträchtigen, so dass die Leber nicht mehr in der Lage ist, ihre Stoffwechsel- und Regulierungsaufgaben effektiv zu erfüllen.
Mit dem Fortschreiten der Krankheit kann sich die Leber zunehmend entzünden und in ihrer Funktion beeinträchtigt werden, was zu Symptomen wie Gelbsucht, Müdigkeit und Bauchschmerzen führt. In schweren Fällen kann eine akute Hepatitis-D-Superinfektion zu Leberversagen und lebensbedrohlichen Komplikationen führen. Die Störung der normalen Leberfunktion durch HDV unterstreicht, wie wichtig es ist, die Biologie des Virus zu verstehen und gezielte Therapien zur Bekämpfung seiner Auswirkungen zu entwickeln.
Arten und Symptome
In diesem Abschnitt befassen wir uns mit den Arten und Symptomen der akuten Hepatitis-D-Superinfektion. Trotz ihres besonderen Schwerpunkts weist die Krankheit eine Reihe von Symptomen und potenziellen Komplikationen auf, die eine gründliche Untersuchung rechtfertigen. Das Verständnis dieser Erscheinungsformen ist für eine genaue Diagnose und eine angemessene Behandlung von entscheidender Bedeutung.
Symptome:
Gelbsucht: Eines der Hauptsymptome einer akuten Hepatitis-D-Superinfektion ist die Gelbsucht, die sich durch eine Gelbfärbung der Haut und der Augen aufgrund eines erhöhten Bilirubinspiegels im Blut bemerkbar macht. Diese Gelbfärbung tritt typischerweise zuerst in den Augen auf und breitet sich dann auf die Haut aus.
Müdigkeit: Patienten mit einer akuten Hepatitis-D-Superinfektion leiden häufig unter ausgeprägter Müdigkeit und Schwäche, was die täglichen Aktivitäten und die Lebensqualität beeinträchtigen kann. Diese Müdigkeit kann auch noch Wochen oder sogar Monate nach dem ersten Auftreten der Symptome anhalten.
Unterleibsschmerzen: Unterleibsschmerzen und Unwohlsein sind häufige Symptome einer akuten Hepatitis-D-Superinfektion, die häufig im rechten oberen Quadranten des Bauches lokalisiert sind. Diese Schmerzen können dumpf oder stechend sein und in ihrer Intensität variieren.
Komplikationen:
Leberversagen: In schweren Fällen kann eine akute Hepatitis-D-Superinfektion zu akutem Leberversagen führen, einem lebensbedrohlichen Zustand, der durch eine schnelle Verschlechterung der Leberfunktion gekennzeichnet ist. Leberversagen kann zu hepatischer Enzephalopathie, Koagulopathie und Multiorganversagen führen.
Chronische Hepatitis: Obwohl eine akute Hepatitis-D-Superinfektion in der Regel innerhalb weniger Wochen abklingt, können einige Personen eine chronische Hepatitis-D-Infektion entwickeln, die durch anhaltende Entzündungen und Leberschäden gekennzeichnet ist. Eine chronische Hepatitis-D-Infektion erhöht das Risiko, eine Zirrhose, ein hepatozelluläres Karzinom und eine Lebererkrankung im Endstadium zu entwickeln.
Fulminante Hepatitis: Fulminante Hepatitis ist eine seltene, aber schwerwiegende Komplikation einer akuten Hepatitis-D-Superinfektion, die durch eine plötzliche und schwere Leberfunktionsstörung gekennzeichnet ist. Dieser Zustand kann zu hepatischer Enzephalopathie, Koma und Tod führen, wenn nicht sofort medizinisch eingegriffen wird.
Eine frühzeitige Erkennung und angemessene Behandlung sind entscheidend, um ein Fortschreiten der Krankheit zu verhindern und die Langzeitfolgen zu minimieren.
Untersuchung und Diagnose
Die Diagnose einer akuten Hepatitis-D-Superinfektion erfordert eine umfassende Untersuchung mit klinischer Untersuchung und Labortests. Eine gründliche Untersuchung hilft bei der genauen Diagnose und der Festlegung geeigneter Behandlungsstrategien.
Klinische Untersuchung:
Eine ausführliche Anamnese ist unerlässlich, um potenzielle Risikofaktoren für eine Hepatitis-D-Superinfektion zu ermitteln, wie z. B. eine Vorgeschichte mit intravenösem Drogenkonsum oder ungeschützter sexueller Aktivität. Die körperliche Untersuchung konzentriert sich auf die Feststellung von Anzeichen einer Lebererkrankung, einschließlich Gelbsucht, Hepatomegalie (vergrößerte Leber) und Druckempfindlichkeit des Abdomens. Außerdem achtet der Arzt auf Symptome einer akuten Leberschädigung, wie Müdigkeit, Übelkeit und Bauchschmerzen.
Labortests und Bildgebung:
Leberfunktionstests (LFTs): Bei LFTs werden die Leberenzymwerte, einschließlich Alanin-Aminotransferase (ALT), Aspartat-Aminotransferase (AST) und Bilirubin, gemessen. Erhöhte ALT- und AST-Werte weisen auf eine hepatozelluläre Schädigung hin, während erhöhte Bilirubinwerte auf eine eingeschränkte Leberfunktion hindeuten können.
Serologische Tests: Serologische Tests weisen spezifische Antikörper gegen das Hepatitis-D-Virus (HDV) nach, darunter Immunglobulin-M-Antikörper (IgM), die auf eine akute Infektion hinweisen, und Immunglobulin-G-Antikörper (IgG), die auf eine frühere oder chronische Infektion hindeuten.
HDV-RNA-Tests: Molekulare Tests, wie die Polymerase-Kettenreaktion (PCR), weisen HDV-RNA in Serum oder Plasma nach, bestätigen die aktive Virusreplikation und helfen bei der Diagnose einer akuten Hepatitis-D-Superinfektion.
Bildgebende Untersuchungen: Ein abdominaler Ultraschall kann durchgeführt werden, um die Größe und Beschaffenheit der Leber sowie das Vorhandensein von fokalen Läsionen zu beurteilen. Bildgebende Untersuchungen sind jedoch bei einer akuten Hepatitis-D-Superinfektion oft unspezifisch und dienen in erster Linie dem Ausschluss anderer Ursachen für eine Lebererkrankung.
Leberbiopsie: In ausgewählten Fällen kann eine Leberbiopsie durchgeführt werden, um das Ausmaß der Leberschädigung zu beurteilen und auf Merkmale einer chronischen Hepatitis-D-Infektion zu achten. Die Leberbiopsie ist jedoch in der Regel Patienten mit atypischen klinischen Symptomen oder dem Verdacht auf eine fortgeschrittene Lebererkrankung vorbehalten.
Diese Diagnosemethoden spielen eine entscheidende Rolle bei der Bestätigung einer akuten Hepatitis-D-Superinfektion, der Bestimmung des Schweregrads der Erkrankung und der Festlegung geeigneter Behandlungsmaßnahmen. Eine frühzeitige Diagnose ermöglicht eine rechtzeitige Einleitung der Therapie und bessere Behandlungsergebnisse für die Patienten.
Therapie und Behandlungen
Die Behandlung der akuten Hepatitis-D-Superinfektion zielt darauf ab, die Leberentzündung zu verringern, die Virusvermehrung zu kontrollieren und Komplikationen zu verhindern. Ein multidisziplinärer Ansatz, an dem Hepatologen, Spezialisten für Infektionskrankheiten und unterstützende Pflegeteams beteiligt sind, ist für eine optimale Behandlung unerlässlich.
Antivirale Therapie:
Interferon-alpha (IFN-α): IFN-α ist die primäre Behandlungsoption für eine akute Hepatitis-D-Superinfektion. Es unterdrückt die virale Replikation, indem es die HDV-RNA-Transkription hemmt und die Immunantwort des Wirts moduliert. Die IFN-α-Therapie wird subkutan für eine bestimmte Dauer verabreicht, die in der Regel zwischen 12 und 24 Wochen liegt.
Pegyliertes Interferon-alpha (PEG-IFN): PEG-IFN, eine modifizierte Form von IFN-α, hat eine längere Halbwertszeit und eine verbesserte Pharmakokinetik, so dass es weniger häufig verabreicht werden muss. Es wird aufgrund seines verbesserten Wirksamkeits- und Verträglichkeitsprofils gegenüber dem Standard-IFN-α bevorzugt.
Unterstützende Behandlung:
Symptomatische Linderung: Die symptomatische Behandlung konzentriert sich auf die Linderung von Symptomen wie Müdigkeit, Übelkeit und Unterleibsbeschwerden. Den Patienten wird geraten, auf eine ausreichende Flüssigkeitszufuhr und Ruhe zu achten.
Unterstützung bei der Ernährung: Bei Patienten mit akuter Hepatitis-D-Superinfektion kann es zu Appetitlosigkeit und Gewichtsverlust kommen. Nahrungsergänzung, einschließlich einer ausgewogenen Ernährung und Vitaminergänzung, unterstützt die Leberfunktion und fördert die Genesung.
Überwachung und Nachsorge:
Leberfunktionstests (LFTs): Regelmäßige LFT-Kontrollen helfen, das Ansprechen auf die Behandlung zu beurteilen und Anomalien der Leberfunktion zu erkennen. LFTs werden in der Regel alle 4 bis 8 Wochen während der Behandlung und zur Nachkontrolle nach der Behandlung durchgeführt.
Überwachung der Viruslast: Die quantitative Messung der HDV-RNA-Spiegel im Serum oder Plasma liefert wertvolle Informationen über die Dynamik der Virusreplikation und die Wirksamkeit der Behandlung. Die serielle Bewertung der Viruslast dient als Richtschnur für die Behandlungsdauer und die Überwachung des Ansprechens.
Lebertransplantation:
In schweren Fällen einer akuten Hepatitis-D-Superinfektion mit fulminantem Leberversagen oder dekompensierter Zirrhose kann eine Lebertransplantation als lebensrettende Maßnahme in Betracht gezogen werden. In Frage kommende Kandidaten werden von einem hepatologischen Transplantationsteam gründlich untersucht, um die Eignung festzustellen und die Transplantation zu priorisieren.
Ergänzende Therapien:
Unterdrückung des Hepatitis-B-Virus (HBV): Da HDV für seine Replikation eine HBV-Koinfektion voraussetzt, wird die gleichzeitige Unterdrückung von HBV mit Nukleos(t)ide-Analoga (z. B. Tenofovir oder Entecavir) empfohlen, um einen HDV-Rückfall zu verhindern.
Immunmodulatorische Mittel: In ausgewählten Fällen können immunmodulatorische Mittel wie Mycophenolatmofetil oder Sirolimus als Zusatztherapie eingesetzt werden, um das Ansprechen auf die Behandlung zu verbessern und ein Fortschreiten der Krankheit zu verhindern.
Klinische Studien:
Die Teilnahme an klinischen Studien zur Bewertung neuer antiviraler Wirkstoffe oder therapeutischer Strategien für die akute Hepatitis-D-Superinfektion kann für Patienten in Betracht gezogen werden, die auf die Standardtherapie nicht ansprechen oder bei denen Kontraindikationen für interferonbasierte Therapien bestehen.
Ursachen und Risikofaktoren
Das Verständnis der Ursachen und Risikofaktoren einer akuten Hepatitis-D-Superinfektion ist entscheidend für eine wirksame Prävention und Behandlung der Krankheit.
Ursachen:
Eine akute Hepatitis-D-Superinfektion tritt auf, wenn eine Person mit einer chronischen Hepatitis-B-Virusinfektion (HBV) mit dem Hepatitis-D-Virus (HDV) koinfiziert wird. HDV ist ein defektes RNA-Virus, das für seine Replikation HBV benötigt. Bei einer Koinfektion nutzt das HDV die Hüllproteine des HBV, um infektiöse Virionen zu bilden. Die daraus resultierende HDV-HBV-Koinfektion führt zu einer schwereren Leberentzündung und einem stärkeren Fortschreiten der Krankheit als eine HBV-Monoinfektion.
Risikofaktoren:
Chronische HBV-Infektion: Personen mit chronischer HBV-Infektion haben ein erhöhtes Risiko, eine akute Hepatitis-D-Superinfektion zu entwickeln. Chronische HBV-Träger dienen als primäres Reservoir für die HDV-Übertragung und erleichtern den Erwerb von HDV durch den Kontakt mit kontaminiertem Blut oder Körperflüssigkeiten.
Parenterale Exposition: Die parenterale Exposition gegenüber infiziertem Blut oder Blutprodukten stellt einen erheblichen Risikofaktor für eine akute Hepatitis-D-Superinfektion dar. Intravenöser Drogenkonsum, unsichere Injektionspraktiken und die berufliche Exposition gegenüber durch Blut übertragbaren Krankheitserregern erhöhen die Wahrscheinlichkeit einer HDV-Übertragung.
Hochriskantes Sexualverhalten: Hochriskante Sexualpraktiken wie ungeschützter Sex mit mehreren Partnern oder mit HBV- oder HDV-infizierten Personen erhöhen das Risiko einer akuten Hepatitis-D-Superinfektion durch sexuelle Übertragung.
Eine chronische HBV-Infektion, eine parenterale Exposition und ein risikoreiches Sexualverhalten sind zwar anerkannte Risikofaktoren für eine akute Hepatitis-D-Superinfektion, doch die individuelle Anfälligkeit kann variieren. Nicht jeder, der diesen Risikofaktoren ausgesetzt ist, wird die Krankheit entwickeln, und zusätzliche Faktoren wie die Immunreaktion des Wirts und die Dynamik der Viruslast können die Anfälligkeit und den Schweregrad der Krankheit beeinflussen.
Krankheitsverlauf und Prognose
Das Verständnis des Verlaufs einer akuten Hepatitis-D-Superinfektion und ihrer Prognose ist für Gesundheitsdienstleister von entscheidender Bedeutung, um Patienten wirksam behandeln zu können. In diesem Abschnitt wird untersucht, wie die Krankheit typischerweise verläuft, und es werden Einblicke in die langfristigen Ergebnisse gegeben.
Verlauf:
Die akute Hepatitis-D-Superinfektion verläuft in der Regel biphasisch. Die erste Phase beginnt mit dem akuten Auftreten von Symptomen wie Gelbsucht, Müdigkeit, Übelkeit, Erbrechen und Unterleibsschmerzen. In dieser Phase vermehrt sich das Virus rasch, was zu einer weit verbreiteten hepatozellulären Schädigung und Entzündung führt. Mit zunehmender Immunreaktion steigen die Leberenzyme wie Alanin-Aminotransferase (ALT) und Aspartat-Aminotransferase (AST) an, was auf eine Leberschädigung hinweist. Wird nicht eingegriffen, kann die Krankheit zu einer fulminanten Hepatitis fortschreiten, die durch schweres Leberversagen und Enzephalopathie gekennzeichnet ist.
In der zweiten Phase, die Wochen bis Monate nach der Erstinfektion eintritt, werden die Patienten entweder vom Virus befreit und die Symptome verschwinden, oder sie entwickeln eine chronische Hepatitis D. In chronischen Fällen führt die anhaltende HDV-Replikation zu einer anhaltenden Leberentzündung und Fibrose, wodurch sich das Risiko einer Zirrhose und eines Leberzellkarzinoms (HCC) mit der Zeit erhöht. Der Krankheitsverlauf ist von Person zu Person unterschiedlich, wobei einige eine rasche Verschlechterung erfahren und andere einen indolenten Verlauf aufweisen.
Prognose:
Die Prognose einer akuten Hepatitis-D-Superinfektion hängt von verschiedenen Faktoren ab, u. a. vom Alter des Patienten, der zugrunde liegenden Leberfunktion, dem Immunstatus und dem Vorhandensein von Komorbiditäten. Bei einer akuten Infektion erholen sich die meisten Patienten innerhalb weniger Monate spontan, wobei die Symptome verschwinden und sich die Leberenzyme normalisieren. Eine fulminante Hepatitis kann jedoch zu akutem Leberversagen und zum Tod führen, wenn sie nicht umgehend durch unterstützende Maßnahmen oder eine Lebertransplantation behandelt wird.
Für Patienten, die eine chronische Hepatitis D entwickeln, ist die Prognose im Allgemeinen weniger günstig. Eine chronische Infektion ist mit einem höheren Risiko einer fortschreitenden Lebererkrankung, einschließlich Zirrhose und HCC, verbunden, was letztlich zu leberbedingter Morbidität und Mortalität führen kann. Die rechtzeitige Einleitung einer antiviralen Therapie und die genaue Überwachung der Leberfunktion sind für die Behandlung der chronischen Hepatitis D und die Minimierung des Risikos langfristiger Komplikationen von entscheidender Bedeutung.
Prävention
Zur Vorbeugung einer akuten Hepatitis-D-Superinfektion gehören verschiedene Strategien, die darauf abzielen, das Risiko einer Exposition gegenüber dem Hepatitis-D-Virus (HDV) zu verringern und die Wahrscheinlichkeit einer Krankheitsübertragung zu minimieren. Durch umfassende Präventionsmaßnahmen können sich Einzelpersonen vor einer Infektion schützen und die Ausbreitung des HDV in Gemeinschaften eindämmen.
Impfung gegen Hepatitis B:
Da das Hepatitis-D-Virus (HDV) für seine Replikation das Hepatitis-B-Virus (HBV) als Helfervirus benötigt, ist die Impfung gegen HBV der Eckpfeiler zur Verhinderung einer Hepatitis-D-Superinfektion. Der Hepatitis-B-Impfstoff bietet eine hochwirksame Langzeitimmunität gegen HBV-Infektionen und verhindert so, dass Personen Träger von HBV werden und anschließend für eine HDV-Infektion anfällig sind.
Allgemeine Vorsichtsmaßnahmen und Infektionskontrolle:
Gesundheitsdienstleister sollten die allgemeinen Vorsichtsmaßnahmen und die Maßnahmen zur Infektionskontrolle einhalten, um die Übertragung von durch Blut übertragbaren Krankheitserregern, einschließlich HDV, zu verhindern. Dazu gehören die Verwendung von persönlicher Schutzausrüstung (z. B. Handschuhe, Masken, Schutzbrillen), ordnungsgemäße Handhygiene, sichere Handhabung und Entsorgung von scharfen/spitzen Gegenständen sowie die Einhaltung von Standard-Sterilisations- und Desinfektionsprotokollen.
Vermeidung von Hochrisikoverhaltensweisen:
Hochriskante Verhaltensweisen wie die gemeinsame Benutzung von Nadeln oder Spritzen, ungeschützter Geschlechtsverkehr mit mehreren Partnern oder Tätowierungen oder Piercings in unkontrollierten Umgebungen erhöhen das Risiko einer HDV-Infektion. Daher sollten die Betroffenen diese Verhaltensweisen vermeiden, um das Risiko einer Exposition gegenüber durch Blut übertragbaren Krankheitserregern, einschließlich HDV, zu minimieren.
Vorsorgeuntersuchungen und Tests:
Regelmäßige Vorsorgeuntersuchungen auf Hepatitis-B- und Hepatitis-D-Infektionen sind unerlässlich, insbesondere für Risikogruppen wie Personen mit injizierendem Drogenkonsum in der Vergangenheit, Männer, die Sex mit Männern haben, Personen mit chronischen Lebererkrankungen und Beschäftigte im Gesundheitswesen. Eine frühzeitige Erkennung von HBV- und HDV-Infektionen ermöglicht ein rechtzeitiges Eingreifen, einschließlich Impfung, Beratung und Behandlung, falls erforderlich.
Gesundheitserziehung und Sensibilisierung:
Die Förderung des öffentlichen Bewusstseins und die Aufklärung über die Übertragung, Prävention und Behandlung von Hepatitis D sind entscheidend für die Verringerung der Krankheitslast. Aufklärungsinitiativen sollten sich darauf konzentrieren, das Wissen über die Bedeutung der Impfung gegen HBV, sichere Injektionspraktiken und die mit Risikoverhaltensweisen verbundenen Risiken zu verbessern. Darüber hinaus kann die Sensibilisierung von Gesundheitsdienstleistern und Risikogruppen eine frühzeitige Erkennung und Intervention erleichtern, was letztlich zu besseren Gesundheitsergebnissen führt.
Zusammenfassung
Die akute Hepatitis-D-Superinfektion, auch bekannt als Delta-Hepatitis, ist eine schwere Lebererkrankung, die auftritt, wenn eine Person mit Hepatitis B auch mit dem Hepatitis-D-Virus infiziert ist. Sie tritt häufiger in Regionen auf, in denen Hepatitis B weit verbreitet ist, wie in Teilen Asiens, Afrikas und des Mittelmeerraums. Die Symptome können schwerwiegend sein, einschließlich Gelbsucht, Müdigkeit und Bauchschmerzen, und können zu Leberversagen oder Tod führen. Die Diagnose erfolgt in der Regel durch serologische Tests und den Nachweis von RNA. Da das Hepatitis-D-Virus für seine Replikation von Hepatitis B abhängig ist, liegt der Schwerpunkt der Prävention auf der Hepatitis-B-Impfung und sicheren Gesundheitspraktiken. In Anbetracht des Schweregrads dieser Erkrankung ist es unerlässlich, die Impfpläne einzuhalten und sichere Verhaltensweisen zu praktizieren, um das Risiko einer Infektion mit Hepatitis B und D zu verringern.